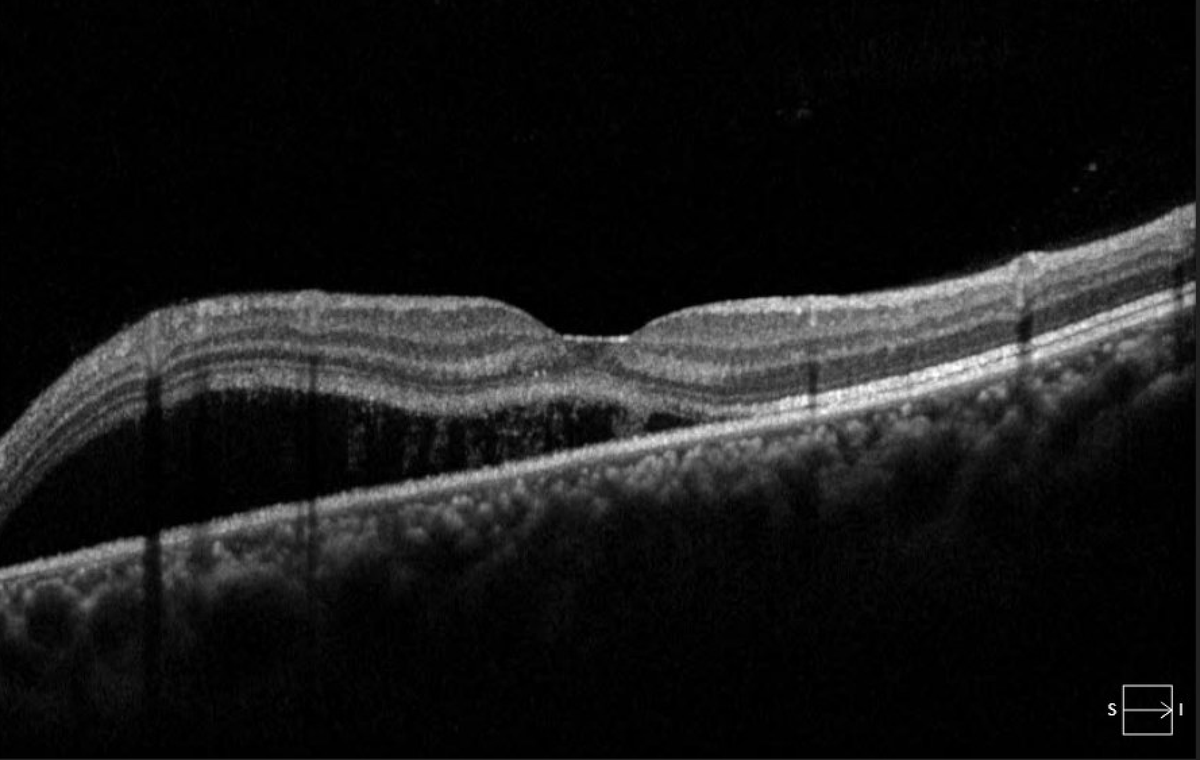
TheRetinaSociety tweet media
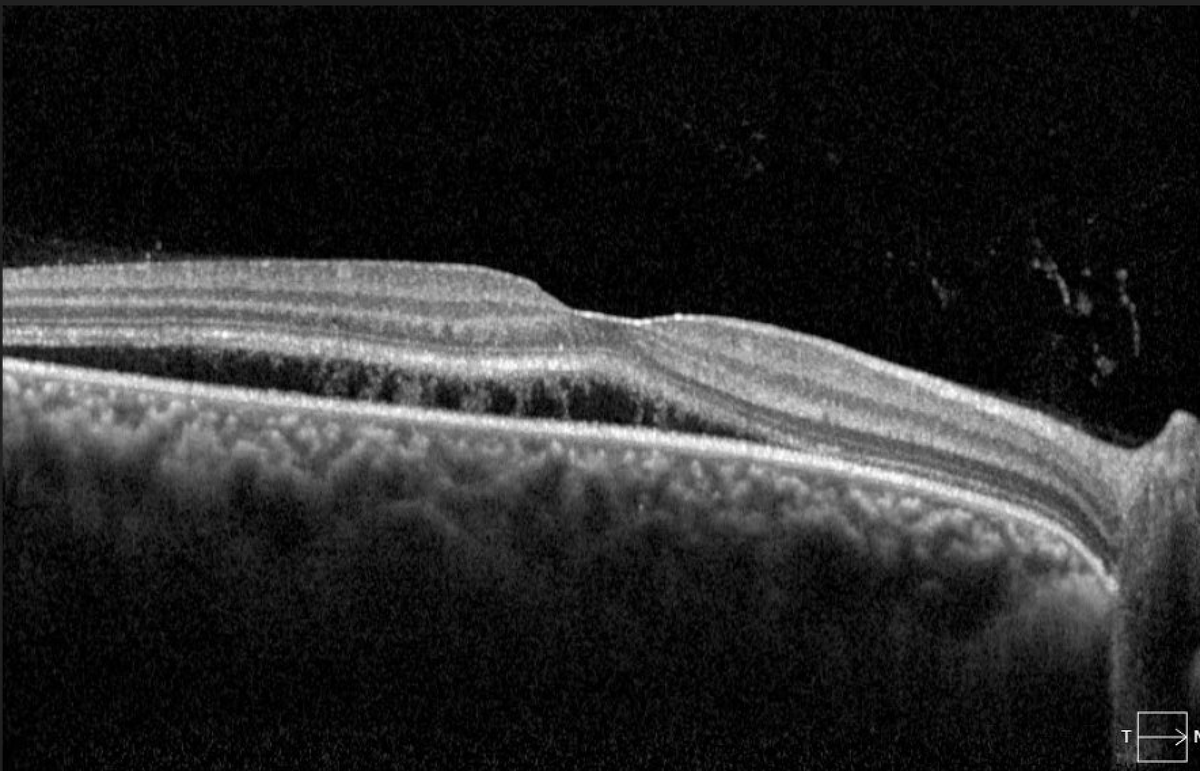
TheRetinaSociety tweet media

Sabitlenmiş Tweet

My first gift from a patient. Fight the good fight, because even if you don’t win, your patients will know they didn’t have to fight alone. We are the collective lighthouse guiding patients during the blinding tempest of disease. #ophthalmology #attending

English